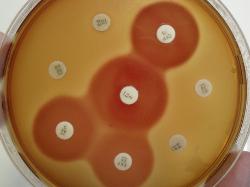
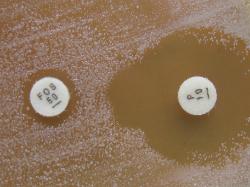
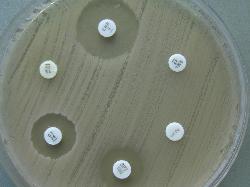
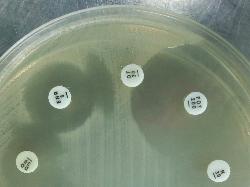
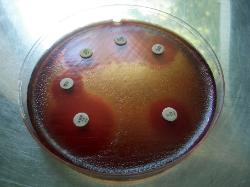
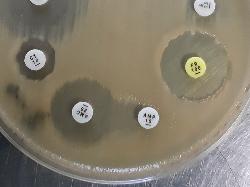

| Antimicrobial Susceptibility Testing |
(c) Costin Stoica
| Antibiogram |
| Encyclopedia |
| Culture media |
| Biochemical tests |
| Stainings |
| Images |
| Movies |
| Articles |
| Identification |
| Software |
| R E G N U M PROKARYOTAE |
| Escherichia coli Antibiogram on Mueller-Hinton medium |
| Beta-hemolytic Streptococcus spp. Antibiogram on Sheep Blood Agar |
The quantitative method (MIC) - based on dilution: serial dilutions of an antimicrobial agent of known
concentration are prepared in growth medium. All tubes are then inoculated with the isolated strain
and incubated for a defined period of time. The MIC is defined as the lowest concentration of
antimicrobial agent needed to inhibit the growth of a test organism. Once the MIC is calculated, it can
be compared to known values for a given species or genera, and antibiotic.
Note: before you perform an antibiogram, you need to identify the strain and be sure you have a pure
culture. The antibiotics used for antibiogram vary for different bacterial genera. Antibiotics selection
must be correlated with strain's characteristics (species/genera), patient (human/animal), and costs
mostly in animal treatment.
The same principle may be applied for antifungigram by using antimycotic-impregnated disks.
concentration are prepared in growth medium. All tubes are then inoculated with the isolated strain
and incubated for a defined period of time. The MIC is defined as the lowest concentration of
antimicrobial agent needed to inhibit the growth of a test organism. Once the MIC is calculated, it can
be compared to known values for a given species or genera, and antibiotic.
Note: before you perform an antibiogram, you need to identify the strain and be sure you have a pure
culture. The antibiotics used for antibiogram vary for different bacterial genera. Antibiotics selection
must be correlated with strain's characteristics (species/genera), patient (human/animal), and costs
mostly in animal treatment.
The same principle may be applied for antifungigram by using antimycotic-impregnated disks.
References:
- Helgomar Raducanescu, Valeria Bica-Popii, 1986, “Bacteriologie veterinara”, Editura Ceres, Bucuresti
- Francois Jehl, Monique Chomarat, Michele Weber, Alain Gerard, 2010. De l'antibiograme a la prescription. 3rd ed, bioMerieux.
- Dumitru Buiuc, Marian Negut, 2009. Tratat de microbiologie clinica. Ed. medicala, 453-481.
- EUCAST - Europeean Comitee On Antimicrobial Susceptibility Testing. Accessed online 10.01.2013, at https://www.eucast.
org/antimicrobial_susceptibility_testing/. - Clinical and Laboratory Standards Institute (CLSI), January 2008. Performance Standards for Antimicrobial Susceptibility
Testing; Eighteenth Informational Supplement, M100-S18, Vol. 28, No. 1.
Antibiogram is an in-vitro testing for the sensitivity of an isolated bacteria strain to different antibiotics.
The main purpose is to help the therapeutic decision, but may also be useful in epidemiological
surveillance or highlighting natural bacterial resistance.
The antibiogram is useless or not recommended in case of non-pathogenic or comensal germs (oral
streptococci, Proteus spp. from cadavers), culture contaminants (Bacillus), or low number of germs in
clinical sample (urine, saliva, sperm).
Two antibiogram methods may be performed in laboratory: diffusimetric (most used and easy to do)
and quantitative.
The diffusimetric method (Kirby-Bauer) - based on the diffusion property of the antibiotic from the
impregnated paper disks. Disks are dispensed on the surface of an bacterial strain inoculated media
(in one or more Petri dishes). EUCAST recommends the utilization of Mueller-Hinton agar without
supplements for non-fastidious organisms, including enterococci, and Mueller-Hinton with 5 % horse
blood and 20 mg β-NAD/L for Streptococcus spp. including Streptococcus pneumoniae, Haemophilus
spp. and other fastidious organisms.
Minimum distance between disks must be 30 mm and minimum distance from plate edge must be
15 mm. Recommended density of inoculum is 0.5 on McFarland scale.
The plates are incubated at 35 ± 1 ºC for 18 ± 2 h within 15 minutes from application of the disks.
Plates are incubated in air for non-fastidious and in air with 5% CO2 for fastidious organisms. During
the incubation the antibiotic will diffuse in the area surrounding each disk, and a rounded clear area
(where the strain's growth is inhibited) will appear.
Reading for non-fastidious germs: measure zone edges as the point showing no growth looking from
the back of the plate against a black background illuminated with reflected light.
Reading for fastidious germs (on blood agar or chocolate agar): measure zone edges as the point
showing no growth viewed from the front of the plate after removing the lid and in reflected light.
The measured diameter (in millimeters) of the clear area is compared with standard tables. See
"Movies" and "Images" sections for more.
Error sources:
- medium quality (nutritivity, pH, humidity), quantity (the thickness of the agar), horizontality & sterility
- incubation conditions (temperature, humidity, atmosphere composition, time)
- low discs quality or expired
- antibiotic interactions
- small distance between discs, or too close to Petri dish margin
- non-standardised inoculum or uneven dispersion in plate
- contaminated culture or bacteriophage infected strain
- reading of the inhibition zones and interpretation (non-standardised measuring instruments)
The main purpose is to help the therapeutic decision, but may also be useful in epidemiological
surveillance or highlighting natural bacterial resistance.
The antibiogram is useless or not recommended in case of non-pathogenic or comensal germs (oral
streptococci, Proteus spp. from cadavers), culture contaminants (Bacillus), or low number of germs in
clinical sample (urine, saliva, sperm).
Two antibiogram methods may be performed in laboratory: diffusimetric (most used and easy to do)
and quantitative.
The diffusimetric method (Kirby-Bauer) - based on the diffusion property of the antibiotic from the
impregnated paper disks. Disks are dispensed on the surface of an bacterial strain inoculated media
(in one or more Petri dishes). EUCAST recommends the utilization of Mueller-Hinton agar without
supplements for non-fastidious organisms, including enterococci, and Mueller-Hinton with 5 % horse
blood and 20 mg β-NAD/L for Streptococcus spp. including Streptococcus pneumoniae, Haemophilus
spp. and other fastidious organisms.
Minimum distance between disks must be 30 mm and minimum distance from plate edge must be
15 mm. Recommended density of inoculum is 0.5 on McFarland scale.
The plates are incubated at 35 ± 1 ºC for 18 ± 2 h within 15 minutes from application of the disks.
Plates are incubated in air for non-fastidious and in air with 5% CO2 for fastidious organisms. During
the incubation the antibiotic will diffuse in the area surrounding each disk, and a rounded clear area
(where the strain's growth is inhibited) will appear.
Reading for non-fastidious germs: measure zone edges as the point showing no growth looking from
the back of the plate against a black background illuminated with reflected light.
Reading for fastidious germs (on blood agar or chocolate agar): measure zone edges as the point
showing no growth viewed from the front of the plate after removing the lid and in reflected light.
The measured diameter (in millimeters) of the clear area is compared with standard tables. See
"Movies" and "Images" sections for more.
Error sources:
- medium quality (nutritivity, pH, humidity), quantity (the thickness of the agar), horizontality & sterility
- incubation conditions (temperature, humidity, atmosphere composition, time)
- low discs quality or expired
- antibiotic interactions
- small distance between discs, or too close to Petri dish margin
- non-standardised inoculum or uneven dispersion in plate
- contaminated culture or bacteriophage infected strain
- reading of the inhibition zones and interpretation (non-standardised measuring instruments)
Figure 1.
Reading the antibiogram - example of possible
antibiotic interactions: antagonism (C + D disks),
synergism (A + B disks and E + F disks). The clear
yellow areas represents the growth inhibition.
No interaction between G and H disks.
Click on picture to enlarge.
Reading the antibiogram - example of possible
antibiotic interactions: antagonism (C + D disks),
synergism (A + B disks and E + F disks). The clear
yellow areas represents the growth inhibition.
No interaction between G and H disks.
Click on picture to enlarge.
| Synergism: (P - Penicillin and FOS - Fosfomycin) |
| Antifungigram (Candida sp.) |
| Synergism (TMP - Trimethoprim, SMZ - Sulphamethoxazole) |
| Synergism (CN - Gentamicin, FFC - Florfenicol) |
| Synergism: Enrofloxacin (ENR) and Tetracyclines (DO - Doxycycline and OT - Oxytetracycline) Escherichia coli antibiogram |
| Mannheimia haemolytica Antibiogram on Sheep Blood Agar |
| Synergism: Ampicillin (AMP) and Amoxicillin+Clavulanic acid (AMC) Klebsiella pneumoniae antibiogram |
| Antibiogram video |
| Inhibition zones |
| NCCLS / CLSI |
| EUCAST |
| Software |
| Back |